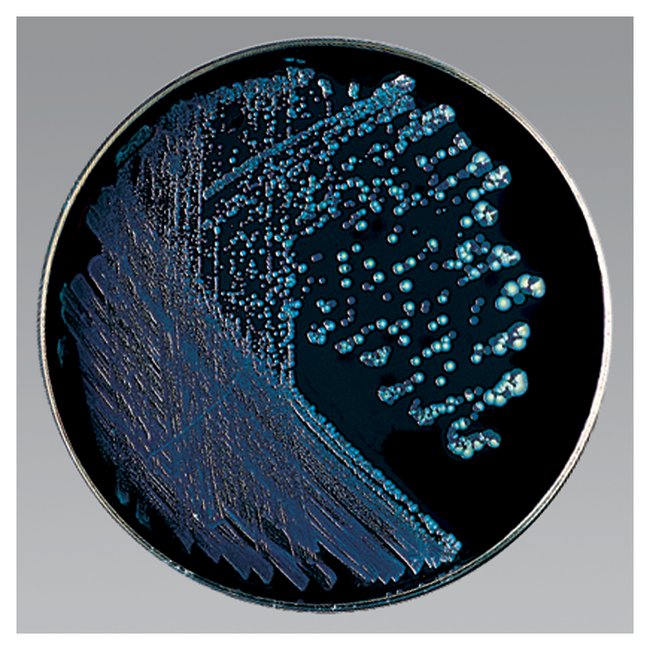

Remel Buffered Cye Differential Agar W/Btb, Bcp, Polymyxin B, Anisomycin, Vancomycin, Use For Isolation And Differentiation Of Legionella Spp, Pack Of 10
|
|
Details:
Thermo Scientific™ Remel Buffered CYE Differential Agar BTB, BCP, Polymyxin B, Anisomycin, Vancomycin (BCYE wDyes PAV) is for isolation and differentiation of Legionella spp.Contains dyes to differentiate Tatlockia micdadei from Legionella pneumophila and antibiotics to suppress contaminating floraThis product(s) resides on a Fisher Scientific GSA or VA contract. If you are viewing this page as a nonregistered user, the price(s) displayed is List Price. To view your GSA or VA contract pricing, log in using your account number, or become a registered user by contacting one of our Customer Service teams. You can also view your contract price by searching for this item(s) on GSA Advantage. To place an order, contact Fisher Scientific Customer Service.
Additional Information
| SKU | 1104784 |
|---|---|
| UOM | Pack of 10 |
| UNSPSC | 12161700 |
| Manufacturer Part Number | R01333 |
